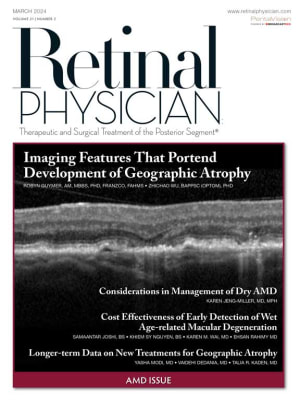

Features
Imaging Features That Portend Development of Geographic Atrophy
Using OCT to identify nascent GA could help prevent vision loss and aid in clinical trial design.
By Robyn Guymer, AM, MBBS, PhD, FRANZCO, FAHMS, Zhichao Wu, BAppSc (Optom), PhD
Cost Effectiveness of Early Detection of Wet Age-related Macular Degeneration
Exploring effective monitoring methods for high-risk conversion patients.
By Samaantar Joshi, BS, Khiem Sy Nguyen, BS, Karen M. Wai, MD, et al.
Considerations in Management of Dry AMD
Patient counseling and logistical considerations are key.
By Karen W. Jeng-Miller, MD, MPH
Web Exclusives
Neovascularization in Macular Telangiectasia
Screening and monitoring are critical elements of care.
By Zack Oakey, MD
Office Workflow Challenges With Anti-complement Therapeutics
Pegcetacoplan and avacincaptad pegol 1 year later
By Priya Vakharia, MD
Eyes Wide Open: Navigating the AI Horizon
The AI revolution can bring practice management and clinical benefits.
By Carrie Jacobs, COE, CPSS, OCS
Positive Results for EYP-1901 in DAVIO 2, and a Look Forward to Phase 3
A promising new class of medications for neovascular AMD patients
By Carl D. Regillo, MD, FACS, Michael A. Singer, MD
Geographic Atrophy: Patient Conversations, Pearls, and Office Workflows
New GA therapeutics require nuanced patient conversations, changes in office workflows, and vigilance to prevent complications in treated eyes.
By Rishabh Gupta, MD, Mathew W. MacCumber, MD, PhD, Vivek Chaturvedi, MD
Departments
Upfront: An Ounce of Prevention
By Peter K. Kaiser, MD
Uveitis Corner: The Management of Uveitis During Pregnancy and Postpartum
Flare rates can change during and after pregnancy.
By Sruthi Arepalli, MD
Clinical Trial Download: Longer-term Data on New Treatments for Geographic Atrophy
Nuances from extension studies will inform therapeutic decision-making.
By Yasha Modi, MD , Vaidehi S. Dedania, MD, Talia R. Kaden, MD
Coding Q&A: Part C Medicare vs Traditional Medicare
Practice managers must understand the implications of the shifting landscape.
By Brandy H. Sperry, COMT, COE, CPC, CPMA
New Product Applications: Fully Digital Bausch + Lomb Surgical Visualization Platform Debuts
New technology provides cutting-edge visualization and ergonomic positioning.
By Karen Appold, contributing writer
Clinical Trial Update March 2024
A listing of all active clinical trials in wet AMD, dry AMD, retinal vein occlusion, diabetic macular edema, and uveitis.
News
Subspecialty News March 2024
Trial results in MacTel, AI in DR screening, industry collaborations, and more.
By Rochelle Nataloni, contributing writer
Retina Fellows Convene in Chicago
John T. Thompson, MD, FASRS, delivered the distinguished guest lecture at the 2024 meeting.
By Carl C. Awh, MD
MCO-010 Gene Therapy Improves BCVA in Patients With Advanced RP
The therapy has received both orphan drug and fast track designations from the FDA.
By Jim Gallagher, senior managing editor